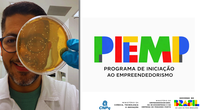

Editais e Oportunidade

Buscando incentivar a cultura da inovação, aqui é possível encontrar algumas notícias e oportunidades para juntos, ampliarmos o ecossistema de inovação na UNILA.
EDITAIS 2026

Edital aberto – Bolsa de Iniciação Tecnológica no NIT/UNILA
Publicado em 20 de março de 2026
A Universidade Federal da Integração Latino-Americana (UNILA), por meio do Núcleo de Inovação Tecnológica e Social (NIT/UNILA), torna pública a abertura de inscrições para a seleção de bolsista de Iniciação Tecnológica, conforme o Edital nº 2/2026/DITEFA.
A iniciativa está vinculada ao Programa de Apoio à Manutenção e Consolidação de Núcleos de Inovação Tecnológica da Fundação Araucária, e tem como objetivo fortalecer as ações de inovação, empreendedorismo e transferência de tecnologia no âmbito da universidade.
Está disponível 1 (uma) vaga para atuação presencial no NIT/UNILA, em Foz do Iguaçu – PR, com carga horária de 40 horas semanais e bolsa no valor de R$ 2.500,00 mensais, com duração de até 17 meses.
Podem participar candidatos com graduação concluída, preferencialmente nas áreas de Comunicação, Direito, Administração, Políticas Públicas ou áreas afins, com interesse em inovação, propriedade intelectual, empreendedorismo e transferência de tecnologia.
Período de inscrição:
13 de março a 15 de abril de 2026
As inscrições devem ser realizadas por meio do sistema Inscreva UNILA: https://inscreva.unila.edu.br/
📄 Confira o edital completo: Acessar edital
A seleção será composta por análise de currículo e entrevista, conforme cronograma estabelecido no edital.
Live de Apresentação do Programa PIEMP – Iniciação ao Empreendedorismo
Publicado em 18 de março de 2026
O Conselho Nacional de Desenvolvimento Científico e Tecnológico (CNPq) convida para a live de apresentação do Programa de Iniciação ao Empreendedorismo (PIEMP), na qual serão apresentados os objetivos, a metodologia do programa e esclarecimentos sobre a Chamada Pública CNPq/MCTI/MEMP Nº 05/2026.
O evento será realizado de forma online no dia 19 de março, das 10h às 11h30, proporcionando um espaço para interação e esclarecimento de dúvidas dos interessados.
🔗 Acesse a live: https://conferenciaweb.rnp.br/cnpq/programa-piemp
O PIEMP tem como objetivo fomentar projetos de empreendedorismo inovador em Instituições Científicas, Tecnológicas e de Inovação (ICTs) e Instituições de Ensino Superior (IES), por meio da concessão de bolsas de Iniciação Tecnológica e Industrial (ITI) para estudantes de graduação.
Prazo para submissão de propostas:
Até 13 de abril de 2026
As inscrições devem ser realizadas por meio da Plataforma Integrada Carlos Chagas: https://carloschagas.cnpq.br/
📄 Confira a chamada pública completa: Acessar edital

Edital aberto – Prêmio Mulheres Inovadoras 2026
Publicado em 16 de março de 2026
A Finep e o Ministério da Ciência, Tecnologia e Inovação (MCTI) lançaram a 7ª edição do Programa Mulheres Inovadoras, iniciativa que busca apoiar startups lideradas por mulheres e ampliar a participação feminina no empreendedorismo inovador no Brasil.
Serão selecionadas até 50 startups, distribuídas pelas cinco regiões do país, em dois estágios de desenvolvimento (validação e tração/escala). As empresas selecionadas participarão de um processo de aceleração com mentorias especializadas.
Premiação total: R$ 3,6 milhões (até R$ 120 mil por startup vencedora)
Período de inscrições:
18 de março a 4 de maio de 2026
Podem participar startups brasileiras com liderança feminina e soluções inovadoras em áreas como inteligência artificial, biotecnologia, IoT, saúde, educação, agritech, cidades inteligentes, bioeconomia, energia renovável e negócios de impacto, entre outras.
🔗 Edital e inscrições: http://www.finep.gov.br/chamadas-publicas/chamadapublica/781
📢 Compartilhe com empreendedoras e startups lideradas por mulheres!
Oportunidade no NIT/UNILA – Bolsa de Iniciação Tecnológica
11/03/2026
Estão abertas as inscrições para 1 vaga de Bolsa de Iniciação Tecnológica no Núcleo de Inovação Tecnológica e Social da UNILA (NIT/UNILA).
Se você é estudante de graduação e tem interesse em inovação, empreendedorismo, propriedade intelectual e transferência de tecnologia, essa é uma oportunidade para atuar diretamente no ecossistema de inovação da universidade.
Informações da bolsa:
💰 Valor: R$ 700,00 mensais
⏱ Carga horária: 20 horas semanais
📍 Atuação presencial no NIT/UNILA – Foz do Iguaçu
⏳ Duração de até 18 meses
Período de inscrição:
01/04/2026 a 16/04/2026
👉 Consulte o edital completo:
https://documentos.unila.edu.br/editais/nit-unila/2-1
___________________________________________________________________________________________________________________

Trilha de Capacitação Empreendedora para Empresas Juniores – Edição 2026
Publicado em 13 de março de 2026
O Núcleo de Inovação Tecnológica e Social da UNILA (NIT/UNILA) convida as Empresas Juniores da universidade para participarem da Oficina 1: Cultura Empreendedora e o DNA da UNILA, que integra a Trilha de Capacitação Empreendedora para Empresas Juniores – edição 2026.
A atividade tem como objetivo fortalecer a cultura empreendedora no ambiente universitário, promovendo reflexões sobre inovação, protagonismo estudantil e o papel das Empresas Juniores no desenvolvimento de soluções e iniciativas dentro da universidade.
Informações da atividade:
📅 Data: 26 de março
⏰ Horário: das 19h às 22h
📍 Local: UNILA – Campus JU | Sala C002
A oficina é aberta a todas as Empresas Juniores da UNILA e representa uma oportunidade de troca de experiências, aprendizado e fortalecimento do ecossistema de inovação e empreendedorismo na universidade.
👉 Todas as EJs estão convidadas. É só chegar!
Mais informações:
📞 (45) 3522-9755 (WhatsApp)
✉️ nucleo.inovacao@unila.edu.br
